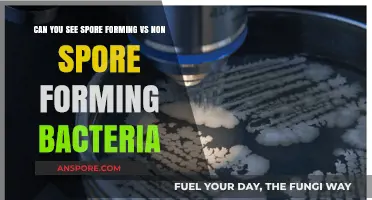
Spore-Forming vs. Non-Spore-Forming Bacteria: Key Differences and Visibility

The presence of spores on contaminated fruits is a significant concern in food safety and agricultural practices. When fruits become contaminated, whether through mold, bacteria, or other pathogens, the question arises: can these fruits still harbor viable spores? Spores are highly resilient structures produced by certain fungi and bacteria, capable of surviving harsh conditions and germinating under favorable environments. Contaminated fruits, if not properly handled or discarded, may serve as carriers of these spores, potentially spreading them to other produce or surfaces. Understanding the persistence of spores on contaminated fruits is crucial for preventing further contamination, ensuring food safety, and minimizing health risks associated with consuming spoiled or moldy produce.
| Characteristics | Values |
|---|---|
| Contaminated Fruits as Source of Spores | Yes, contaminated fruits can still harbor and release spores, especially from fungi like molds. |
| Common Fungi Involved | Aspergillus, Penicillium, Fusarium, and various species of molds. |
| Spores Survival on Fruits | Spores can survive on fruits even after contamination, depending on environmental conditions (humidity, temperature). |
| Spores Release Mechanism | Spores are released into the air when the fruit decomposes or is disturbed (e.g., cutting, handling). |
| Health Risks | Inhalation of spores can cause allergic reactions, respiratory issues, or infections in immunocompromised individuals. |
| Prevention Methods | Proper storage, refrigeration, and prompt removal of contaminated fruits to prevent spore spread. |
| Detection Methods | Visual inspection, mold growth, and laboratory testing for spore presence. |
| Environmental Factors Affecting Spores | High humidity and warm temperatures promote spore growth and release. |
| Cross-Contamination Risk | Spores can spread to other fruits or surfaces if not contained properly. |
| Longevity of Spores | Spores can remain viable for extended periods, even after the fruit has been removed. |
Explore related products
What You'll Learn
- Identifying Contaminated Fruits: Learn visual cues like mold, discoloration, or unusual textures indicating spore presence
- Safety Risks of Spores: Understand health hazards from consuming spores on contaminated fruits
- Methods to Extract Spores: Techniques for safely isolating spores from contaminated fruit surfaces
- Preventing Fruit Contamination: Best practices to minimize spore growth on stored fruits
- Using Contaminated Spores: Potential applications or risks of spores from contaminated fruits

Identifying Contaminated Fruits: Learn visual cues like mold, discoloration, or unusual textures indicating spore presence
Fruits, nature's candy, can sometimes hide a sinister surprise: spores from mold and other contaminants. Knowing how to spot these visual cues is crucial for anyone looking to maintain a healthy diet. The first and most obvious sign of contamination is mold. This fuzzy or powdery growth can appear in various colors, such as green, black, or white, and often starts in small patches before spreading. For instance, strawberries with mold should be discarded immediately, as the spores can penetrate the fruit's surface, making it unsafe to consume even if you cut off the affected area.
Discoloration is another key indicator of spore presence. While some fruits naturally change color as they ripen, abnormal discoloration—such as brown or black spots on apples or oranges—can signal fungal growth. These spots may feel softer than the surrounding flesh, a texture change that often accompanies contamination. For example, a banana with dark, mushy patches is likely hosting spores, and consuming it could lead to digestive issues or allergic reactions.
Unusual textures are equally telling. Healthy fruits typically have a consistent texture, whether smooth, firm, or juicy. If you notice sliminess, stickiness, or an overly soft feel, it’s a red flag. Grapes, for instance, should be plump and firm; if they feel wrinkled or mushy, they’ve likely been compromised by spores. Even if only a few fruits in a bunch show these signs, it’s best to discard the entire cluster, as spores can spread quickly.
To effectively identify contaminated fruits, follow these practical steps: inspect fruits under good lighting, gently press the surface to check for softness, and sniff for any off-putting odors. For children and the elderly, who are more susceptible to foodborne illnesses, it’s especially important to be vigilant. Always wash fruits thoroughly before consumption, but remember that washing won’t eliminate spores already embedded in the fruit.
In conclusion, mastering the art of spotting mold, discoloration, and unusual textures can safeguard your health and that of your loved ones. By staying alert to these visual cues, you can enjoy fruits without the risk of spore-related contamination.
Are Spores Gram-Positive? Unraveling the Bacterial Classification Mystery
You may want to see also

Safety Risks of Spores: Understand health hazards from consuming spores on contaminated fruits
Consuming spores from contaminated fruits can pose significant health risks, particularly when these spores belong to harmful fungi or bacteria. For instance, *Aspergillus* and *Fusarium* species, commonly found on moldy fruits, produce mycotoxins that can cause acute and chronic illnesses. Even small amounts of these toxins, such as aflatoxins, can lead to liver damage, cancer, or severe gastrointestinal distress. Unlike surface contaminants, spores can penetrate the fruit’s flesh, making washing or peeling ineffective in removing them entirely.
To minimize exposure, inspect fruits for visible mold, bruising, or unusual discoloration before consumption. While not all spores are harmful, those from toxic species can remain viable even after refrigeration or mild cooking. For example, *Clostridium botulinum* spores, though rare on fruits, can survive boiling temperatures and cause botulism if ingested. Vulnerable populations, including children, pregnant women, and immunocompromised individuals, are at higher risk and should avoid fruits showing any signs of spoilage.
Practical steps can reduce spore-related risks. Discard fruits with moldy patches, as spores may have spread beyond visible areas. Store fruits properly—keep them dry, refrigerated, and separated from ethylene-producing items like apples, which accelerate ripening and spoilage. For processed fruits, ensure products are pasteurized or treated to eliminate spores. Fermented foods, while generally safe, should be sourced from reputable producers to avoid contamination during preparation.
Comparatively, while bacterial spores like *Bacillus cereus* are less common on fruits, fungal spores are more prevalent and persistent. Unlike bacteria, fungi thrive in low-moisture environments, making dried fruits particularly susceptible. A study found that 30% of dried figs tested positive for *Aspergillus* spores, highlighting the need for rigorous quality control in food production. Consumers should prioritize fresh, undamaged fruits and avoid homemade preserves unless prepared under sterile conditions.
In conclusion, understanding spore-related health hazards empowers safer fruit consumption. By recognizing risks, adopting preventive measures, and staying informed, individuals can protect themselves from spore-induced illnesses. While not all spores are dangerous, the potential for toxicity underscores the importance of vigilance in food selection and storage.
Using Spore Syringes on Agar Dishes: Techniques and Best Practices
You may want to see also

Methods to Extract Spores: Techniques for safely isolating spores from contaminated fruit surfaces
Spores from contaminated fruits can indeed be extracted, but the process requires precision to ensure safety and purity. One effective method is the surface sterilization technique, which involves treating the fruit’s exterior with a sterilizing agent to eliminate surface contaminants while preserving the spores. A common protocol includes immersing the fruit in a 70% ethanol solution for 1–2 minutes, followed by a 2–3% sodium hypochlorite (bleach) treatment for 3–5 minutes, and finally rinsing with sterile distilled water. This sequence minimizes microbial competition and isolates viable spores for further analysis.
Another approach is the blender-wash method, ideal for fruits with rugged surfaces or embedded spores. The fruit is blended in a sterile buffer solution, typically phosphate-buffered saline (PBS), to dislodge spores from the tissue. The resulting slurry is then filtered through a series of sieves or sterile gauze to remove large debris. Subsequent centrifugation at 3,000–4,000 rpm for 10–15 minutes allows spore separation from lighter contaminants. This method is particularly useful for fungi like *Aspergillus* or *Penicillium*, which often colonize fruits internally.
For researchers seeking a non-destructive technique, adhesive tape sampling offers a viable alternative. A piece of sterile adhesive tape is gently pressed onto the fruit’s surface to capture spores without damaging the fruit. The tape is then transferred to a microscope slide or nutrient agar plate for spore identification and culturing. This method is less invasive but may yield lower spore quantities compared to more aggressive techniques. It’s best suited for preliminary assessments or when preserving the fruit’s integrity is critical.
Regardless of the method chosen, sterility and safety precautions are paramount. All equipment must be sterilized using autoclaving or chemical disinfection, and work should be conducted in a biosafety cabinet to prevent airborne contamination. Personal protective equipment, including gloves, lab coats, and face shields, is essential when handling potentially pathogenic spores. Proper disposal of contaminated materials and decontamination of workspaces post-procedure are equally critical to avoid cross-contamination.
In conclusion, extracting spores from contaminated fruits is feasible with the right techniques, but success hinges on meticulous execution and adherence to safety protocols. Whether employing surface sterilization, blender-wash methods, or adhesive tape sampling, each approach offers unique advantages tailored to specific research needs. By balancing precision with caution, scientists can safely isolate spores for study, contributing to advancements in fields like mycology, food safety, and plant pathology.
Are Spores a Yeast? Unraveling the Microbial Mystery
You may want to see also
Explore related products

Preventing Fruit Contamination: Best practices to minimize spore growth on stored fruits
Spores from contaminated fruits can persist even after visible mold is removed, making prevention of spore growth critical during storage. These microscopic structures are resilient, surviving harsh conditions and germinating when favorable environments return. Understanding this tenacity underscores the importance of proactive measures to protect stored fruits.
Control Humidity and Temperature: Spores thrive in damp, warm conditions. Maintain storage areas at optimal humidity levels (below 60%) and temperatures (0–4°C for most fruits) to inhibit germination. For example, apples stored at 3°C with 85–90% relative humidity retain quality longer, while higher temperatures accelerate decay. Use dehumidifiers or proper ventilation in storage rooms, and avoid overcrowding fruits, which traps moisture.
Sanitize Storage Environments: Spores can linger on surfaces, ready to contaminate fresh produce. Regularly clean storage containers, shelves, and tools with a 10% bleach solution (1 part bleach to 9 parts water) or food-grade sanitizers. For organic operations, use vinegar-based solutions, though their efficacy is lower. Ensure all equipment is dried thoroughly before use to prevent residual moisture from fostering spore growth.
Inspect and Isolate: Before storing, meticulously inspect fruits for signs of damage, bruising, or mold. Even small lesions can harbor spores. Isolate or discard compromised fruits immediately, as spores can spread via air or contact. For instance, a single moldy strawberry in a container can contaminate an entire batch within days. Implement a "first in, first out" system to minimize prolonged storage and reduce risk.
Natural Antimicrobials: Incorporate natural agents to suppress spore growth. For example, essential oils like thyme or oregano (diluted to 1–2% concentration) can be applied as surface sprays. Alternatively, packaging fruits with antimicrobial films or coatings, such as chitosan or edible films infused with cinnamon extract, has shown promise in extending shelf life by inhibiting spore germination.
Post-Harvest Treatments: Treat fruits with hot water (50–55°C for 10–20 minutes) or ultraviolet (UV-C) light to reduce surface spore loads before storage. These methods are particularly effective for thick-skinned fruits like citrus or melons. However, avoid excessive heat for delicate fruits like berries, opting instead for milder treatments like chlorine washes (50–200 ppm) to balance efficacy and safety.
By combining these practices—environmental control, sanitation, inspection, natural interventions, and targeted treatments—growers and consumers can significantly minimize spore growth on stored fruits, preserving quality and safety.
Can Mold Spores Trigger Skin Hives? Understanding the Allergic Reaction
You may want to see also

Using Contaminated Spores: Potential applications or risks of spores from contaminated fruits
Contaminated fruits often harbor spores from fungi like *Aspergillus*, *Penicillium*, or *Fusarium*, which thrive in decaying organic matter. While these spores are typically associated with food spoilage or mycotoxin production, they also possess untapped potential. For instance, certain fungal spores can degrade complex organic compounds, making them candidates for bioremediation. However, their use requires careful consideration of risks, such as unintended environmental contamination or human health hazards. This duality—potential utility versus inherent danger—frames the exploration of using spores from contaminated fruits.
One practical application lies in wastewater treatment. Spores from *Trichoderma* or *Aspergillus* species, commonly found on moldy fruits, exhibit enzymatic activity that breaks down pollutants like dyes or pesticides. To harness this, a controlled inoculation of these spores into treatment systems could enhance biodegradation. For example, a study found that *Aspergillus niger* spores reduced textile dye concentrations by 70% within 48 hours. However, implementation demands strict containment to prevent spore dispersal, as inhalation of these fungi can cause respiratory issues, particularly in immunocompromised individuals or those with pre-existing lung conditions.
Another avenue is agriculture, where contaminated fruit spores could be repurposed as biofertilizers or biopesticides. For instance, *Trichoderma* spores, often present on decaying apples or grapes, can suppress soil-borne pathogens like *Rhizoctonia* or *Fusarium*. Farmers could create spore suspensions by fermenting contaminated fruit residues in water (1 kg of moldy fruit per 10 liters of water for 7 days), straining the mixture, and applying it to soil at a rate of 1 liter per 10 square meters. Yet, this approach risks introducing mycotoxins into the soil, potentially affecting crop safety. Regular soil testing for toxins like aflatoxins or ochratoxins is essential to mitigate this risk.
From a persuasive standpoint, the circular economy model supports repurposing contaminated fruit spores. Instead of discarding moldy produce, bioprocessing facilities could extract spores for industrial applications, reducing waste and creating value. For example, *Penicillium* spores, notorious for spoiling citrus fruits, produce enzymes like pectinase, used in food processing. However, scaling such initiatives requires regulatory frameworks to ensure safety, including spore viability testing and toxin screening. Without these safeguards, the benefits of spore reuse could be overshadowed by public health or environmental crises.
In conclusion, spores from contaminated fruits present a paradox: they are both a problem and a resource. Their applications in bioremediation, agriculture, and industry are promising but demand meticulous risk management. By balancing innovation with caution, we can transform a byproduct of spoilage into a tool for sustainability, provided we address the inherent challenges of toxicity, containment, and regulation.
Can Mold Spores Appear in Urine After a Month of Exposure?
You may want to see also
Frequently asked questions
Yes, spores from contaminants like mold or bacteria can be present on fruits even if they appear healthy, as some spores are invisible to the naked eye.
Spores can survive on contaminated fruits for weeks to months, depending on environmental conditions like humidity, temperature, and storage.
Washing can reduce the number of spores, but it may not remove them entirely, especially if the contamination has penetrated the fruit's surface.
Yes, ingesting spores from contaminated fruits can lead to foodborne illnesses, allergic reactions, or infections, depending on the type of contaminant.